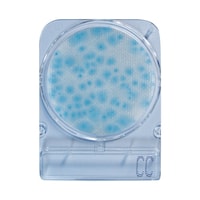
�R���p�N�g�h���C�H�i�J�e�L�����a�ܓ����ʐ��ې�����p�j�@�P���i�S���~�U�O�ܓ��j�@�O�S�Q�X�X�@�P��
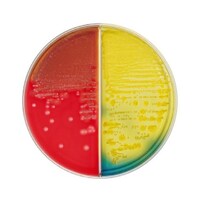
���{�x�N�g���E�f�B�b�L���\���@�a�c�@�a�a�k�i�s�l�j�@�s�r�`�h�h�T���q�c�W���t���V�|�n�^�a�s�a���������V�|�n�@�Q�O��

極東製薬工業 極東 CLIG寒天生培地 50本入 07521
大腸菌の確認及び、腸管出血性大腸菌O157鑑別が容易にできます。高層部で乳糖からの酸産生、斜面部でセロビオースからの酸産生が確認できます。
大腸菌の確認及び、腸管出血性大腸菌O157鑑別が容易にできます。高層部で乳糖からの酸産生、斜面部でセロビオースからの酸産生が確認できます。+もっと見る
日本ベクトン・ディッキンソン BD BBL(TM) CDC嫌気性菌用5%ヒツジ血液寒天培地 20枚 251733 培地 簡易培地 1個(20枚)
CDC嫌気性菌用ヒツジ血液寒天培地は、CDC(CenterforDiseaseControl)によって開発された、偏性嫌気性菌の分離、培養の非選択培地です
CDC嫌気性菌用ヒツジ血液寒天培地は、CDC(CenterforDiseaseControl)によって開発された、偏性嫌気性菌の分離、培養の非選択培地です+もっと見る
Merck ICRプラスコンタクトプレート (含有成分:レシチン、ポリソルベート80、ヒスチジン、チオサルフェート)1箱(20枚入) 1.46501.0020
三重包装になっており、アイソレーターやクリーンルームの環境測定培地として使用可能です。フタを回すことで容易にロックできますので、落としてもはずれず二次汚染が防げます。
三重包装になっており、アイソレーターやクリーンルームの環境測定培地として使用可能です。フタを回すことで容易にロックできますので、落としてもはずれず二次汚染が防げます。+もっと見る
Merck リステリア測定用培地 フレーザーリステリア選択剤 リステリアの二次増菌 1箱(10本入) 1.00093.0010
Readybag(R)で一次増菌を行った後、選択増菌及び選択分離を行います。フレーザー・リステリア増菌ブイヨン基礎培地(6881471)に添加して使用します。
Readybag(R)で一次増菌を行った後、選択増菌及び選択分離を行います。フレーザー・リステリア増菌ブイヨン基礎培地(6881471)に添加して使用します。+もっと見る
三愛オブリ イージーディップ 微生物簡易測定器具 硫化物産生菌測定用 SANAI EZDip 1箱(9本入) S
特別な設備はいらず、現場環境でも測定できます。培養後、対照表を比較するだけで測定できます。汚染菌を容易に検出できます。
特別な設備はいらず、現場環境でも測定できます。培養後、対照表を比較するだけで測定できます。汚染菌を容易に検出できます。+もっと見る
栄研化学 バイメディアR5S+A/CTSMAC SP寒天培地 100枚入 EMR09 1箱
サルモネラ・シゲラ及びO157分離用分画培地サルモネラ・シゲラ及びO157の発育支持力と集落の鑑別性能が優れています。緑膿菌の発育抑制力を増強しています。
サルモネラ・シゲラ及びO157分離用分画培地サルモネラ・シゲラ及びO157の発育支持力と集落の鑑別性能が優れています。緑膿菌の発育抑制力を増強しています。+もっと見る
日本ベクトン・ディッキンソン BD BBL(TM) ミューラーヒントン5%ヒツジ血液寒天培地 20枚
ミューラーヒントン5%ヒツジ血液寒天培地は、ミューラーヒントンII寒天培地に脱線維ヒツジ血液を添加したもので、通常のミューラーヒントンII寒天培地では満足な発育を示さないStreptococcusなど
ミューラーヒントン5%ヒツジ血液寒天培地は、ミューラーヒントンII寒天培地に脱線維ヒツジ血液を添加したもので、通常のミューラーヒントンII寒天培地では満足な発育を示さないStreptococcusなど+もっと見る
JNC MCMedia Pad ACplus(RAC) 一般生菌用迅速/一般生菌用 兼用 (1000枚) SK01A25
手軽にかつ正確な微生物検査が可能です。サンプルを培地パッドに滴下するだけですので、不慣れな方でも取り扱いが容易です。経験の差が出にくくなります。
手軽にかつ正確な微生物検査が可能です。サンプルを培地パッドに滴下するだけですので、不慣れな方でも取り扱いが容易です。経験の差が出にくくなります。+もっと見る
日本ベクトン・ディッキンソン BD BBL(TM) サブローデキストロースCG寒天培地 20枚 251359 培地 簡易培地 1個(20枚)
サブローデキストロースCG寒天培地はサブローデキストロース寒天培地にクロラムフェニコール、ゲンタマイシンを添加することにより、様々な検査材料から病原性あるいは非病原性の真菌を分離するのにおすすめ
サブローデキストロースCG寒天培地はサブローデキストロース寒天培地にクロラムフェニコール、ゲンタマイシンを添加することにより、様々な検査材料から病原性あるいは非病原性の真菌を分離するのにおすすめ+もっと見る
日本ベクトン・ディッキンソン BD BBL(TM) バシトラシン添加チョコレート2寒天培地 20枚 256271 培地 その他 1個(20枚)
バシトラシン添加チョコレートII寒天培地は、チョコレートII寒天培地〔GCII寒天培地を基礎としてヘモグロビンとエンリッチメント(アイソバイタルX)を加えた培地〕にバシトラシンを添加した培地です。
バシトラシン添加チョコレートII寒天培地は、チョコレートII寒天培地〔GCII寒天培地を基礎としてヘモグロビンとエンリッチメント(アイソバイタルX)を加えた培地〕にバシトラシンを添加した培地です。+もっと見る
Merck リステリア測定用培地 フレーザーリステリア鉄(III)選択剤 リステリアの二次増菌 1箱(10本入) 1.00092.0010
Readybag(R)で一次増菌を行った後、選択増菌及び選択分離を行います。フレーザー・リステリア増菌ブイヨン基礎培地(6881471)に添加して使用します。
Readybag(R)で一次増菌を行った後、選択増菌及び選択分離を行います。フレーザー・リステリア増菌ブイヨン基礎培地(6881471)に添加して使用します。+もっと見る
コンパクトドライ (リステリア・モノサイトゲネス/4枚×10袋入) 06531LM
培地調製の不要な菌数測定用の培地です。接種した試料液は自然に均一に拡散します。発育した集落は着色するため菌数の計測が容易です。発育集落の釣菌が可能です。
培地調製の不要な菌数測定用の培地です。接種した試料液は自然に均一に拡散します。発育した集落は着色するため菌数の計測が容易です。発育集落の釣菌が可能です。+もっと見る
コンパクトドライ (リステリア・モノサイトゲネス/4枚×60袋入) 06532LM
培地調製の不要な菌数測定用の培地です。接種した試料液は自然に均一に拡散します。発育した集落は着色するため菌数の計測が容易です。発育集落の釣菌が可能です。
培地調製の不要な菌数測定用の培地です。接種した試料液は自然に均一に拡散します。発育した集落は着色するため菌数の計測が容易です。発育集落の釣菌が可能です。+もっと見る
日本ベクトン・ディッキンソン BD BBL(TM) ミューラーヒントン5%ヒツジ血液寒天培地(150mm) 24枚
ミューラーヒントン5%ヒツジ血液寒天培地は、ミューラーヒントンII寒天培地に脱線維ヒツジ血液を添加したもので、通常のミューラーヒントンII寒天培地では満足な発育を示さないStreptococcusなど
ミューラーヒントン5%ヒツジ血液寒天培地は、ミューラーヒントンII寒天培地に脱線維ヒツジ血液を添加したもので、通常のミューラーヒントンII寒天培地では満足な発育を示さないStreptococcusなど+もっと見る
日本ベクトン・ディッキンソン BD BBL(TM) ソルビトール添加マッコンキーII寒天培地 20枚
ソルビトール添加マッコンキーII寒天培地は、グラム陰性桿菌用の選択培地であるマッコンキーII寒天培地の乳糖をソルビトールに置き換えることにより、病原性大腸菌O157とそれ以外のE. coliとを容易に
ソルビトール添加マッコンキーII寒天培地は、グラム陰性桿菌用の選択培地であるマッコンキーII寒天培地の乳糖をソルビトールに置き換えることにより、病原性大腸菌O157とそれ以外のE. coliとを容易に+もっと見る
エルメックス XgalMUG培地 10mL XM30
1mL検体液用です。大腸菌群・E.coli同時検査用培地です。色と光で大腸菌群・E.coliが同時検査可能です。24時間で検出が可能かつ、EMB培地等を用いた追加試験や確定試験が不要です。
1mL検体液用です。大腸菌群・E.coli同時検査用培地です。色と光で大腸菌群・E.coliが同時検査可能です。24時間で検出が可能かつ、EMB培地等を用いた追加試験や確定試験が不要です。+もっと見る
エルメックス 新採便管 FC20
腸内細菌検査用、保存培地が入り採便管です機械塗抹も可能です。検体保存に適したキャリブレア培地を使用しています。pH指示薬により、採便前(青色)と採便後(黄色)が明確に分かります。
腸内細菌検査用、保存培地が入り採便管です機械塗抹も可能です。検体保存に適したキャリブレア培地を使用しています。pH指示薬により、採便前(青色)と採便後(黄色)が明確に分かります。+もっと見る
Merck アンプル培地
+もっと見る
キッコーマンバイオ 【冷蔵】EasyPlate CC 大腸菌群測定用
粉末培地の調製や事前のオートクレーブ滅菌が不要で、不意の検査にもすぐに対応できます。混釈・重層の必要がなく、作業時間も短縮可能です。発色剤を使用していますので、コロニーと残渣との判別が容易です。AOA
粉末培地の調製や事前のオートクレーブ滅菌が不要で、不意の検査にもすぐに対応できます。混釈・重層の必要がなく、作業時間も短縮可能です。発色剤を使用していますので、コロニーと残渣との判別が容易です。AOA+もっと見る
日本ベクトン・ディッキンソン BD BBL(TM) CA添加5%ヒツジ血液寒天培地/マッコンキーII寒天培地LDIP 20枚
ヒツジ血液寒天培地(M)にコリスチンとアズトレオナムを添加し、グラム陽性菌の選択に適した血液寒天培地と、グラム陰性桿菌の選択分離培地であるマッコンキーII寒天培地の組み合わせです。
ヒツジ血液寒天培地(M)にコリスチンとアズトレオナムを添加し、グラム陽性菌の選択に適した血液寒天培地と、グラム陰性桿菌の選択分離培地であるマッコンキーII寒天培地の組み合わせです。+もっと見る
サン化学 サンコリ検体作製水(希釈水)1箱(100本入) 144
サン滅菌綿棒を使ったふき取り検査時や滅菌サンパックを使った食品検査の希釈時に使用する生理食塩水です。手で簡単に開けられます。滅菌サンパックと滅菌計量棒を使用することで希釈倍率を行えます。
サン滅菌綿棒を使ったふき取り検査時や滅菌サンパックを使った食品検査の希釈時に使用する生理食塩水です。手で簡単に開けられます。滅菌サンパックと滅菌計量棒を使用することで希釈倍率を行えます。+もっと見る
栄研化学 ぺたんチェックRII25 トリプトソイ寒天培地 1箱(10枚×4袋入) PK0009
器具・培地調整等の事前準備が不要で、1人で容易に操作できます。汚染実態の把握・消毒殺菌効果判定が肉眼ででき、また汚染源の特定菌の有無を判定することができます。
器具・培地調整等の事前準備が不要で、1人で容易に操作できます。汚染実態の把握・消毒殺菌効果判定が肉眼ででき、また汚染源の特定菌の有無を判定することができます。+もっと見る
栄研化学 ぺたんチェックRII25 標準寒天培地 1箱(10枚×4袋入) PK0001
器具・培地調整等の事前準備が不要で、1人で容易に操作できます。汚染実態の把握・消毒殺菌効果判定が肉眼ででき、また汚染源の特定菌の有無を判定することができます。
器具・培地調整等の事前準備が不要で、1人で容易に操作できます。汚染実態の把握・消毒殺菌効果判定が肉眼ででき、また汚染源の特定菌の有無を判定することができます。+もっと見る
栄研化学 ぺたんチェックRII25 デスオキシコーレイト寒天培地 1箱(10枚×4袋入) PK0002
器具・培地調整等の事前準備が不要で、1人で容易に操作できます。汚染実態の把握・消毒殺菌効果判定が肉眼ででき、また汚染源の特定菌の有無を判定することができます。
器具・培地調整等の事前準備が不要で、1人で容易に操作できます。汚染実態の把握・消毒殺菌効果判定が肉眼ででき、また汚染源の特定菌の有無を判定することができます。+もっと見る
栄研化学 ぺたんチェックRII25 サブロー寒天培地 1箱(10枚×4袋入) PK0008
器具・培地調整等の事前準備が不要で、1人で容易に操作できます。汚染実態の把握・消毒殺菌効果判定が肉眼ででき、また汚染源の特定菌の有無を判定することができます。
器具・培地調整等の事前準備が不要で、1人で容易に操作できます。汚染実態の把握・消毒殺菌効果判定が肉眼ででき、また汚染源の特定菌の有無を判定することができます。+もっと見る
栄研化学 ぺたんチェックRII25 SCDLP寒天培地 1箱(10枚×4袋入) PK0010
器具・培地調整等の事前準備が不要で、1人で容易に操作できます。汚染実態の把握・消毒殺菌効果判定が肉眼ででき、また汚染源の特定菌の有無を判定することができます。
器具・培地調整等の事前準備が不要で、1人で容易に操作できます。汚染実態の把握・消毒殺菌効果判定が肉眼ででき、また汚染源の特定菌の有無を判定することができます。+もっと見る
柴田科学 一般細菌試験紙 080510シリーズ
+もっと見る
極東製薬工業 極東 無菌卵黄液 50mL×6 1箱(6本入) 04005 培地 培地(食品検査用) 1箱(6本入)
生理食塩水により50%に調節したγ線滅菌済の卵黄液です。滅菌調節し、4550℃に冷えた培地に必要量を添加する事ですぐに使用できます。
生理食塩水により50%に調節したγ線滅菌済の卵黄液です。滅菌調節し、4550℃に冷えた培地に必要量を添加する事ですぐに使用できます。+もっと見る
Merck 無菌試験用液体培地 ボトル チオグリコレート液体培地 1箱(10本入) 1.46406.0010
無菌試験専用の液体培地です。キャップ形状はシリンジ挿入用にセプタムキャップになっています。シリンジ挿入部の汚染防止キャップ付です。検査時における内容物視認性確保のため、透明なラベルを採用しています。
無菌試験専用の液体培地です。キャップ形状はシリンジ挿入用にセプタムキャップになっています。シリンジ挿入部の汚染防止キャップ付です。検査時における内容物視認性確保のため、透明なラベルを採用しています。+もっと見る
Merck 無菌試験用液体培地 ボトル チオグリコレート液体培地 1箱(10本入) 1.46386.0010
無菌試験専用の液体培地です。キャップ形状はシリンジ挿入用にセプタムキャップになっています。シリンジ挿入部の汚染防止キャップ付です。検査時における内容物視認性確保のため、透明なラベルを採用しています。
無菌試験専用の液体培地です。キャップ形状はシリンジ挿入用にセプタムキャップになっています。シリンジ挿入部の汚染防止キャップ付です。検査時における内容物視認性確保のため、透明なラベルを採用しています。+もっと見る
Merck 無菌試験用液体培地 ボトル チオグリコレート液体培地(透明)1箱(10本入) 1.46456.0010
無菌試験専用の液体培地です。キャップ形状はシリンジ挿入用にセプタムキャップになっています。シリンジ挿入部の汚染防止キャップ付です。検査時における内容物視認性確保のため、透明なラベルを採用しています。
無菌試験専用の液体培地です。キャップ形状はシリンジ挿入用にセプタムキャップになっています。シリンジ挿入部の汚染防止キャップ付です。検査時における内容物視認性確保のため、透明なラベルを採用しています。+もっと見る
Merck 無菌試験用液体培地 ボトル チオグリコレート液体培地(透明)1箱(10本入) 1.46333.0010
無菌試験専用の液体培地です。キャップ形状はシリンジ挿入用にセプタムキャップになっています。シリンジ挿入部の汚染防止キャップ付です。検査時における内容物視認性確保のため、透明なラベルを採用しています。
無菌試験専用の液体培地です。キャップ形状はシリンジ挿入用にセプタムキャップになっています。シリンジ挿入部の汚染防止キャップ付です。検査時における内容物視認性確保のため、透明なラベルを採用しています。+もっと見る
Merck 無菌試験用液体培地 ボトル SCD液体培地 1箱(10本入) 1.46317.0010
無菌試験専用の液体培地です。キャップ形状はシリンジ挿入用にセプタムキャップになっています。シリンジ挿入部の汚染防止キャップ付です。検査時における内容物視認性確保のため、透明なラベルを採用しています。
無菌試験専用の液体培地です。キャップ形状はシリンジ挿入用にセプタムキャップになっています。シリンジ挿入部の汚染防止キャップ付です。検査時における内容物視認性確保のため、透明なラベルを採用しています。+もっと見る
Merck 無菌試験用液体培地 ボトル SCD液体培地 1箱(10本入) 1.46380.0010
無菌試験専用の液体培地です。キャップ形状はシリンジ挿入用にセプタムキャップになっています。シリンジ挿入部の汚染防止キャップ付です。検査時における内容物視認性確保のため、透明なラベルを採用しています。
無菌試験専用の液体培地です。キャップ形状はシリンジ挿入用にセプタムキャップになっています。シリンジ挿入部の汚染防止キャップ付です。検査時における内容物視認性確保のため、透明なラベルを採用しています。+もっと見る
キッコーマンバイオ 【冷蔵】EasyPlate AC 一般生菌数測定用
粉末培地の調製や事前のオートクレーブ滅菌が不要で、不意の検査にもすぐに対応できます。混釈・重層の必要がなく、作業時間も短縮可能です。発色剤を使用していますので、コロニーと残渣との判別が容易です。AOA
粉末培地の調製や事前のオートクレーブ滅菌が不要で、不意の検査にもすぐに対応できます。混釈・重層の必要がなく、作業時間も短縮可能です。発色剤を使用していますので、コロニーと残渣との判別が容易です。AOA+もっと見る
キッコーマンバイオ 【冷蔵】EasyPlate EC 大腸菌・大腸菌群測定用
粉末培地の調製や事前のオートクレーブ滅菌が不要で、不意の検査にもすぐに対応できます。混釈・重層の必要がなく、作業時間も短縮可能です。発色剤を使用していますので、コロニーと残渣との判別が容易です。AOA
粉末培地の調製や事前のオートクレーブ滅菌が不要で、不意の検査にもすぐに対応できます。混釈・重層の必要がなく、作業時間も短縮可能です。発色剤を使用していますので、コロニーと残渣との判別が容易です。AOA+もっと見る
キッコーマンバイオ 【冷蔵】EasyPlate SA 黄色ブドウ球菌数測定用
粉末培地の調製や事前のオートクレーブ滅菌が一切不要で、不意の検査にもすぐに対応できます。希釈・重層の必要がなく、操作が簡単で使いやすく、作業時間も短縮可能です。従来の寒天培地で、卵黄反応が陰性判定の黄
粉末培地の調製や事前のオートクレーブ滅菌が一切不要で、不意の検査にもすぐに対応できます。希釈・重層の必要がなく、操作が簡単で使いやすく、作業時間も短縮可能です。従来の寒天培地で、卵黄反応が陰性判定の黄+もっと見る
コンパクトドライ?(カテキン中和剤入り一般生菌数測定用) 1箱(4枚×60袋入) 04299 1箱
培地調製の不要な菌数測定用の培地です。接種した試料液は自然に均一に拡散します。発育した集落は着色するため菌数の計測が容易です。発育集落の釣菌が可能です。
培地調製の不要な菌数測定用の培地です。接種した試料液は自然に均一に拡散します。発育した集落は着色するため菌数の計測が容易です。発育集落の釣菌が可能です。+もっと見る
日本ベクトン・ディッキンソン BD BBL(TM) TSAII5%ヒツジ血液寒天培地/チョコレートII寒天培地 20枚
本培地は、1枚で2種類の培地が併用できる様に組合わされた便利で効率の良い培地で、発育性、溶血反応にすぐれた一般分離用のTSAII5%ヒツジ血液寒天培地とHaemophilus、Neisseria など
本培地は、1枚で2種類の培地が併用できる様に組合わされた便利で効率の良い培地で、発育性、溶血反応にすぐれた一般分離用のTSAII5%ヒツジ血液寒天培地とHaemophilus、Neisseria など+もっと見る
栄研化学 ぺたんチェックRII25 卵黄加マンニット食塩寒天培地 1箱(10枚×4袋入) PK0004
器具・培地調整等の事前準備が不要で、1人で容易に操作できます。汚染実態の把握・消毒殺菌効果判定が肉眼ででき、また汚染源の特定菌の有無を判定することができます。
器具・培地調整等の事前準備が不要で、1人で容易に操作できます。汚染実態の把握・消毒殺菌効果判定が肉眼ででき、また汚染源の特定菌の有無を判定することができます。+もっと見る
栄研化学 ぺたんチェックRII25 CP加ポテトデキストロース寒天培地 1箱(10枚×4袋入) PK0007
器具・培地調整等の事前準備が不要で、1人で容易に操作できます。汚染実態の把握・消毒殺菌効果判定が肉眼ででき、また汚染源の特定菌の有無を判定することができます。
器具・培地調整等の事前準備が不要で、1人で容易に操作できます。汚染実態の把握・消毒殺菌効果判定が肉眼ででき、また汚染源の特定菌の有無を判定することができます。+もっと見る
サン化学 簡易菌検出紙
+もっと見る
JNC 【冷蔵】MCMedia Pad ACplus(RAC) 一般生菌用迅速/一般生菌用 兼用 (100枚)
手軽にかつ正確な微生物検査が可能です。サンプルを培地パッドに滴下するだけですので、不慣れな方でも取り扱いが容易です。経験の差が出にくくなります。発育した菌は特徴的な発色コロニーを形成しますので、判定が
手軽にかつ正確な微生物検査が可能です。サンプルを培地パッドに滴下するだけですので、不慣れな方でも取り扱いが容易です。経験の差が出にくくなります。発育した菌は特徴的な発色コロニーを形成しますので、判定が+もっと見る
日本ベクトン・ディッキンソン BD BBL(TM) TSAII5%ヒツジ血液寒天培地/マッコンキーII寒天培地 20枚
本培地は、1枚で2種類の培地が併用できる様に組合わされた便利で効率の良い培地で、発育性、溶血反応にすぐれた一般分離用TSA II5%ヒツジ血液寒天培地と、グラム陰性桿菌の選択分離にすぐれたマッコンキー
本培地は、1枚で2種類の培地が併用できる様に組合わされた便利で効率の良い培地で、発育性、溶血反応にすぐれた一般分離用TSA II5%ヒツジ血液寒天培地と、グラム陰性桿菌の選択分離にすぐれたマッコンキー+もっと見る
JNC MCMedia Pad EB 腸内細菌科菌群用
+もっと見る
クリーンスタンプ25
+もっと見る
日本ベクトン・ディッキンソン BD BBL(TM) TSAII5%ヒツジ血液寒天培地/BTB乳糖加寒天培地 20枚
本培地は、1枚で2種類の培地が併用できる様に組合わされた便利で効率の良い培地で、発育性、溶血反応にすぐれた一般分離用TSA II5%ヒツジ血液寒天培地と、グラム陰性桿菌の非選択培地であるBTB 乳糖加
本培地は、1枚で2種類の培地が併用できる様に組合わされた便利で効率の良い培地で、発育性、溶血反応にすぐれた一般分離用TSA II5%ヒツジ血液寒天培地と、グラム陰性桿菌の非選択培地であるBTB 乳糖加+もっと見る